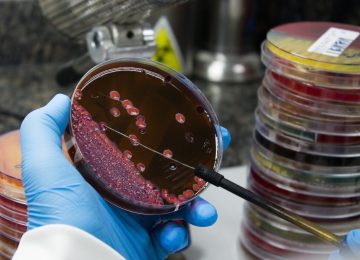

¿Qué aprenderás en este curso?
Competencia general de aprendizaje:
Explicar los principios fundamentales de la microbiología clínica.
Competencias específicas
- Distinguir las características morfológicas de bacterias y hongos en muestras clínicas para su correcta identificación y clasificación.
- Aplicar los criterios taxonómicos para clasificar bacterias y hongos
- Describir los modelos de interacción huésped-parásitos en la Microbiología clínica.
- Resumir los medios y condiciones ambientales adecuadas para la identificación precisa de microorganismos de interés clínico.
- Comparar los métodos de susceptibilidad.
- Esquematizar los tipos de antimicrobianos y sus mecanismos de acción.
Duración: 8 semanas.
Carga horaria: 30 horas de estudio.
Aula: guiasdemicro.com
- Atención personalizada
- Aprendizaje basado en casos clínicos
- Actividades interactivas
- Bibliografía científica
- Foros de discusión
- Flexibilidad de aprendizaje
- Aula disponible permanentemente
- Experiencias significativas
Facilitadora
Lcda. Carolina Macero.
Esp. en Bacteriología clínica.
MÓDULO 1
Unidad 1. Breve reseña histórica de la Microbiología.
Unidad 2. Conceptos básicos de las enfermedades infecciosas.
Actividades propuestas en aula: un foro y un chat
Materiales: 4 videos, 2 lecturas, 2 autoevaluaciones, 2 ejercicios
Tiempo sugerido: 3 horas para completar
MÓDULO 2
Unidad 3. Células procariotas y eucariotas
Actividades propuestas en aula: un foro y un chat
Materiales: 4 videos, 2 lecturas, 2 autoevaluaciones, 2 ejercicios
Tiempo sugerido: 3 horas para completar
MÓDULO 3
Unidad 4. Microorganismos de importancia clínica: aerobios y anaerobios facultativos, anaerobios estrictos, micobacterias, levaduras y mohos.
Actividades propuestas en aula: dos foros y dos chats
Materiales: 6 videos, 6 lecturas, 6 autoevaluaciones, 4 ejercicios
Tiempo sugerido: 6 horas para completar
MÓDULO 4
Unidad 5. Examen directo, coloraciones, medios de cultivo, aislamiento e identificación.
Actividades propuestas en aula: 2 foros y 2 chats
Materiales: 6 videos, 4 lecturas, 6 autoevaluaciones, 6 ejercicios
Tiempo sugerido: 6 horas para completar
MÓDULO 5
Unidad 6. Introducción a los antimicrobianos.
Actividades propuestas en aula: un foro y un chat
Materiales: 4 videos, 4 lecturas, 2 autoevaluaciones, 2 ejercicios
Tiempo sugerido: 4 horas para completar
MÓDULO 6
Unidad 7. Fundamentos de las pruebas de susceptibilidad.
Actividades propuestas en aula: un foro y un chat
Materiales: 2 videos, 2 lecturas, 2 autoevaluaciones, 2 ejercicios
Tiempo sugerido: 4 horas para completar
MÓDULO 7
Repaso del contenido.
Actividades propuestas en aula: un foro y dos chats.
Tiempo sugerido: 3 horas de dedicación.
MÓDULO 8
Prueba final
Actividades propuestas en el aula:
Evaluación final, foro de finalización y encuesta.
Entrega de certificados.
La microbiología clínica es una disciplina fundamental para el diagnóstico, tratamiento y prevención de las enfermedades infecciosas, ya que permite identificar con precisión su etiología y orientar terapias adecuadas. Este curso ofrece una introducción completa a los conceptos básicos que sustentan esta área, proporcionando a los profesionales de la salud, en formación y en ejercicio, una base sólida para su comprensión. Sin este conocimiento, es imposible tomar decisiones clínicas precisas y efectivas.
 Actualmente, el dominio de este importante tema es más vital que nunca. La microbiología no solo se limita al laboratorio, sino que se extiende a cada faceta de la atención médica, impactando directamente en la toma de decisiones.
Actualmente, el dominio de este importante tema es más vital que nunca. La microbiología no solo se limita al laboratorio, sino que se extiende a cada faceta de la atención médica, impactando directamente en la toma de decisiones.
Este curso ha sido diseñado para proporcionar las bases esenciales para entender por qué y cómo los microorganismos afectan la salud humana. Su diseño garantiza la obtención de recursos y herramientas para ser aplicados en los distintos campos.
El entendimiento de la naturaleza de los microorganismos que causan enfermedades, su forma de interacción con el cuerpo humano, y las técnicas para su identificación y control son piezas claves para interpretar, de manera acertada, los resultados de los estudios microbiológicos, optimizar el diagnóstico y contribuir a un tratamiento más eficaz, impactando significativamente en el desempeño de los participantes como agentes de cambio en la lucha contra las enfermedades infecciosas.
Esp. Carolina Macero
Bacterióloga clínica.
Fundadora y facilitadora de Guías de Micro.
Coordinadora del Dpto. de Microbiología del Instituto Médico La Floresta.
Docente de los postgrados de Infectología del Hospital Universitario de Caracas y Hospital Militar «Carlos Arvelo».
Miembro de la Sociedad Venezolana de Bioanalistas Especialistas, Sociedad Venezolana de Microbiología, Sociedad Venezolana de Infectología y American Society for Microbiology.

